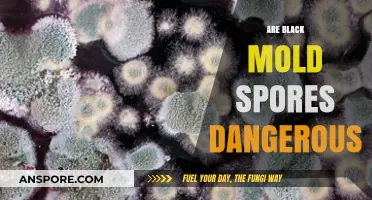
Are Black Mold Spores Dangerous? Uncovering the Health Risks and Facts
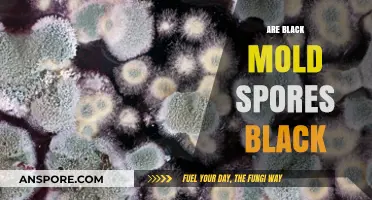
Are Black Mold Spores Black? Unveiling the Truth Behind the Color

Black mold, scientifically known as *Stachybotrys chartarum*, is a type of fungus notorious for its potential health risks and dark, slimy appearance. One common concern surrounding black mold is whether its spores are airborne, as this directly impacts its spread and the likelihood of human exposure. Mold spores, including those from black mold, are naturally lightweight and can become airborne when disturbed, such as during cleaning, construction, or even everyday activities. Once airborne, these spores can travel through the air, settle on surfaces, or be inhaled, posing health risks such as allergic reactions, respiratory issues, and, in severe cases, more serious conditions for individuals with compromised immune systems. Understanding whether black mold spores are airborne is crucial for effective prevention, detection, and remediation strategies to protect indoor air quality and human health.
| Characteristics | Values |
|---|---|
| Airborne Nature | Yes, black mold spores are lightweight and can become airborne easily. |
| Size of Spores | Typically 3-10 microns in diameter, small enough to float in the air. |
| Dispersal Mechanism | Released into the air through disturbance (e.g., touching, airflow). |
| Survival in Air | Can remain suspended in air for long periods, depending on conditions. |
| Health Risks | Inhalation can cause allergic reactions, respiratory issues, and other health problems, especially in sensitive individuals. |
| Detection in Air | Air quality tests can detect airborne mold spores. |
| Prevention | Reduce moisture, improve ventilation, and promptly address mold growth to minimize spore release. |
| Common Locations | Found in damp areas like bathrooms, basements, and areas with water damage. |
| Visibility in Air | Not visible to the naked eye when airborne. |
| Settling Time | Spores eventually settle on surfaces but can recirculate with movement. |
Explore related products
What You'll Learn

How black mold spores become airborne
Black mold spores are remarkably lightweight, measuring between 3 to 10 microns in size—smaller than a grain of sand. This minuscule dimension allows them to remain suspended in air currents for extended periods, making them inherently airborne. However, their journey into the air isn’t spontaneous. It requires specific conditions, such as disturbance of the mold colony, to dislodge the spores from their surface. Once airborne, these spores can travel through ventilation systems, open windows, or even cling to clothing, spreading far beyond their original source.
Mechanisms of Dispersal: How Spores Take Flight
Black mold spores become airborne primarily through physical disruption of the mold growth. Common culprits include brushing against moldy surfaces, vacuuming contaminated areas without a HEPA filter, or even the air movement from fans or HVAC systems. For instance, during renovation or cleanup, scraping mold off walls can release millions of spores into the air. Similarly, everyday activities like opening windows in a damp basement or running a dehumidifier can stir up spores, especially if mold is present on hidden surfaces like drywall or insulation.
Environmental Factors: The Role of Humidity and Airflow
High humidity levels (above 60%) create an ideal environment for mold growth and spore release. As mold colonies mature, they produce spores in greater quantities, increasing the likelihood of airborne dispersal. Airflow, whether natural or mechanical, acts as a catalyst. For example, a ceiling fan in a moldy bathroom can inadvertently spread spores throughout the room. Even temperature changes, such as warm air hitting a cold surface, can cause condensation and disturb mold colonies, releasing spores into the air.
Practical Prevention: Minimizing Airborne Spores
To reduce airborne black mold spores, start by addressing moisture sources—fix leaks, use exhaust fans, and maintain indoor humidity below 50%. During cleanup, avoid dry brushing or sweeping moldy areas; instead, use a damp cloth or vacuum with a HEPA filter. Always wear an N95 respirator and protective clothing to avoid inhaling spores or carrying them to other areas. For large infestations, consult professionals who use containment barriers and negative air pressure to prevent spore spread during remediation.
Health Implications: Why Airborne Spores Matter
Inhaling airborne black mold spores can trigger allergic reactions, respiratory issues, and in severe cases, toxic effects from mycotoxins. Vulnerable populations, such as children, the elderly, and those with compromised immune systems, are at higher risk. For example, prolonged exposure to Stachybotrys chartarum (a type of black mold) has been linked to chronic sinusitis and bronchitis. Monitoring indoor air quality and promptly addressing mold growth are critical steps in safeguarding health. Regularly inspecting hidden areas like crawlspaces and attics can prevent spore release before it becomes a problem.
Do All Bacteria Form Spores? Unraveling Microbial Survival Strategies
You may want to see also

Health risks of inhaling black mold spores
Black mold spores are indeed airborne, making them easy to inhale without even realizing it. These microscopic particles can float through the air, settling in your respiratory system when you breathe. While not everyone reacts to them, prolonged or intense exposure can lead to serious health issues. Understanding the risks is the first step in protecting yourself and your loved ones.
Inhaling black mold spores can trigger a range of respiratory problems, especially in individuals with pre-existing conditions. Asthma sufferers, for instance, may experience more frequent and severe attacks. Chronic coughing, wheezing, and shortness of breath are common symptoms, even in otherwise healthy adults. Children, whose immune systems are still developing, are particularly vulnerable. Studies show that early exposure to mold spores can increase the risk of asthma in kids by up to 30%. If you notice persistent respiratory symptoms, consider testing your home for mold, especially in damp areas like basements or bathrooms.
The immune system also takes a hit when exposed to black mold spores. Prolonged inhalation can lead to chronic inflammation, making the body more susceptible to infections. People with compromised immune systems, such as those undergoing chemotherapy or living with HIV, face even greater risks. Mold spores can cause fungal infections in the lungs, a condition known as aspergillosis, which requires immediate medical attention. To minimize exposure, improve ventilation in your home, fix leaks promptly, and maintain humidity levels below 50%.
Another lesser-known risk is the neurological impact of inhaling black mold spores. Some individuals report headaches, memory loss, and even mood disorders after prolonged exposure. While research is still ongoing, mycotoxins produced by black mold are believed to play a role in these symptoms. If you suspect mold is affecting your cognitive health, consult a healthcare professional and take steps to eliminate the source. Using air purifiers with HEPA filters can help reduce spore counts in your living spaces.
Prevention is key when it comes to protecting yourself from the health risks of black mold spores. Regularly inspect your home for signs of mold, such as musty odors or visible growth. Keep areas prone to moisture, like kitchens and bathrooms, clean and dry. If you find mold, address it immediately—small patches can often be cleaned with a solution of bleach and water, but larger infestations may require professional remediation. By staying vigilant, you can reduce the likelihood of inhaling these harmful spores and safeguard your health.
Are All Gram-Positive Bacteria Non-Spore Forming? Unraveling the Myth
You may want to see also

Conditions that increase spore air dispersal
Black mold spores are lightweight and easily become airborne under the right conditions, dispersing widely to colonize new areas. Understanding the factors that enhance their air dispersal is crucial for preventing mold growth and protecting indoor air quality. Several environmental and physical conditions can significantly increase the likelihood of spores taking to the air.
Humidity and Moisture Levels: High humidity and moisture are primary catalysts for mold spore release. When relative humidity exceeds 60%, mold growth accelerates, and spores are more likely to detach from colonies. Water-damaged materials, such as damp drywall or carpet, provide ideal breeding grounds. For instance, a leaky roof or pipe can create conditions where spores are continuously released into the air. To mitigate this, maintain indoor humidity below 50% using dehumidifiers and promptly repair water leaks.
Airflow and Disturbance: Physical disturbances, like air movement from fans, HVAC systems, or even human activity, can dislodge spores from surfaces. Opening windows in mold-prone areas during windy conditions may inadvertently increase spore dispersal indoors. Similarly, vacuuming without a HEPA filter can aerosolize spores, spreading them throughout a space. When cleaning moldy areas, use damp methods to minimize airborne particles and ensure proper ventilation without creating drafts that could disperse spores.
Temperature Fluctuations: Mold thrives in temperatures between 68°F and 86°F (20°C and 30°C), but temperature changes can also trigger spore release. For example, warming a cold, damp basement in winter may cause spores to become airborne as the air dries. Seasonal transitions, like spring and fall, often see increased spore dispersal due to fluctuating temperatures and humidity. Monitor indoor climates during these periods and take preventive measures, such as insulating cold surfaces and using air purifiers with HEPA filters.
Material Degradation: As mold consumes organic materials like wood, paper, or fabric, the weakening structure can cause spores to detach more easily. Older buildings with deteriorating drywall or wallpaper are particularly susceptible. Regularly inspect vulnerable materials and replace them if signs of mold appear. For at-risk areas, consider using mold-resistant products, such as treated lumber or mildew-resistant paints, to reduce spore dispersal risks.
By addressing these conditions—humidity, airflow, temperature, and material integrity—you can significantly reduce the airborne dispersal of black mold spores. Proactive measures not only protect indoor air quality but also prevent the health risks associated with mold exposure, such as allergies, respiratory issues, and more severe conditions in vulnerable populations like children, the elderly, and immunocompromised individuals.
Mastering Mushroom Cultivation: A Guide to Growing Spores Successfully
You may want to see also
Explore related products

Detecting airborne black mold spores indoors
Black mold spores are indeed airborne, making them a pervasive and often invisible threat in indoor environments. These microscopic particles can travel through the air, settle on surfaces, and even be inhaled, posing health risks such as allergic reactions, respiratory issues, and more severe complications for immunocompromised individuals. Detecting airborne black mold spores indoors requires a combination of vigilance, tools, and strategies to identify their presence before they become a major problem.
Step-by-Step Detection Methods
Begin with a visual inspection of areas prone to moisture, such as basements, bathrooms, and kitchens. Look for dark, speckled patches on walls, ceilings, or grout, which may indicate mold growth. However, airborne spores are often invisible, so rely on tools like air quality testers or mold test kits. Air quality monitors can detect particulate matter (PM) levels, with elevated PM 2.5 or PM 10 readings suggesting the presence of spores. For a more targeted approach, use a mold test kit that collects air or surface samples for lab analysis. Follow the kit’s instructions carefully, ensuring you test multiple areas, especially near HVAC vents where spores can circulate.
Cautions and Limitations
While DIY methods are accessible, they have limitations. Air quality monitors may not differentiate between mold spores and other particles like dust or pollen. Mold test kits, though accurate, can take days for lab results and may not pinpoint the exact source of spores. Additionally, false negatives can occur if spores are not evenly distributed in the air. For precise detection, consider hiring a professional mold inspector equipped with advanced tools like spore traps or thermal imaging to identify hidden moisture sources.
Practical Tips for Effective Detection
To maximize detection accuracy, test during periods of high humidity or after recent water damage, as spores are more likely to be airborne. Keep windows closed during testing to avoid outdoor contamination. If using an air quality monitor, place it at breathing height (3–5 feet) for 24–48 hours to capture a representative sample. For mold test kits, collect samples in the morning when spore concentrations are typically higher. Regularly inspect and maintain HVAC systems, as clogged filters or ductwork can harbor and distribute spores.
Health-Focused Takeaway
Early detection of airborne black mold spores is critical for safeguarding health, particularly for children, the elderly, and those with respiratory conditions. Persistent symptoms like coughing, sneezing, or skin irritation in the absence of other allergens may indicate spore exposure. If detected, address the source promptly by fixing leaks, improving ventilation, and using HEPA air purifiers to reduce spore counts. Remember, while detection tools are valuable, prevention through moisture control remains the most effective strategy to keep indoor air safe.
Ozone's Power: Effectively Eliminating Mold Spores in Your Environment
You may want to see also

Preventing black mold spore airborne spread
Black mold spores are indeed airborne, making them a silent threat to indoor air quality and human health. These microscopic particles can travel through the air, settle on surfaces, and even be inhaled, potentially causing respiratory issues and allergic reactions. Understanding their airborne nature is the first step in devising effective strategies to prevent their spread.
Containment and Isolation: A Proactive Approach
When dealing with black mold, containment is key. The primary goal is to prevent spores from becoming airborne and spreading to unaffected areas. This is particularly crucial during mold remediation processes. Professionals often use physical barriers, such as plastic sheeting, to isolate the affected area. Negative air pressure machines are employed to ensure that air flows into the contained space, trapping spores and preventing their escape. For DIY enthusiasts tackling small-scale mold issues, it's essential to seal off the work area with plastic sheets and use fans to direct air outward, preferably through a window, to minimize spore dispersion.
The Role of Air Purifiers and Filtration
Air purifiers equipped with High-Efficiency Particulate Air (HEPA) filters are powerful tools in the fight against airborne mold spores. These devices capture particles as small as 0.3 microns, effectively trapping mold spores and preventing their circulation. For optimal results, place air purifiers in high-risk areas, such as basements or bathrooms, and ensure they are appropriately sized for the room. Regular filter replacement is critical; a clogged filter can reduce efficiency and potentially release trapped spores back into the air.
Moisture Control: Addressing the Root Cause
Preventing black mold spore spread is not just about managing the spores themselves but also about tackling the underlying cause: moisture. Mold thrives in damp environments, so maintaining indoor humidity below 60% is essential. Dehumidifiers can be invaluable in humid climates or areas prone to moisture buildup, such as basements. Promptly fixing leaks, ensuring proper ventilation in bathrooms and kitchens, and regularly inspecting plumbing can significantly reduce the risk of mold growth and subsequent spore release.
Cleaning and Disinfection Techniques
Regular cleaning with mold-inhibiting solutions is a proactive measure to prevent spore spread. For non-porous surfaces, a mixture of bleach and water (1 cup of bleach per gallon of water) is effective. However, this should be used with caution, as bleach can be harmful if not properly diluted and ventilated. Alternatively, commercial mold removal products or natural solutions like vinegar or baking soda can be used. Porous materials, such as drywall or ceiling tiles, often require replacement if mold infestation is severe, as spores can penetrate deeply and are difficult to eradicate completely.
In the battle against airborne black mold spores, a multi-faceted approach is necessary. From containment strategies during remediation to ongoing moisture control and air purification, each measure plays a vital role in maintaining a healthy indoor environment. By understanding the airborne nature of these spores, homeowners and professionals can implement targeted solutions, ensuring that black mold remains a manageable issue rather than a pervasive health hazard.
Can Heat Kill Mold Spores? Effective Temperatures and Methods Explained
You may want to see also
Frequently asked questions
Yes, black mold spores are airborne. They can become suspended in the air when mold-infested materials are disturbed, allowing them to spread to other areas.
Black mold spores become airborne through activities like cleaning, construction, or even air movement. Disturbing moldy surfaces releases spores into the air, where they can travel and settle elsewhere.
Yes, airborne black mold spores can cause health problems, especially in individuals with allergies, asthma, or weakened immune systems. Symptoms may include coughing, sneezing, skin irritation, and respiratory issues.
To reduce airborne black mold spores, maintain low humidity levels, fix leaks promptly, improve ventilation, and clean moldy areas with proper protective gear. Using air purifiers with HEPA filters can also help.
Yes, airborne black mold spores can grow in new locations if they land on damp, organic materials and find suitable conditions, such as warmth and moisture. Preventing moisture buildup is key to stopping their growth.